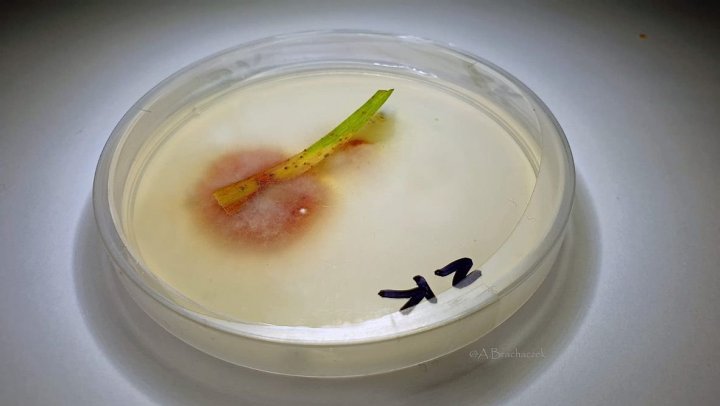
fuzarioza.jpeg

Oziminy zagrożone. Zacznij wiosnę od zabiegu T0
Symptomy zagrożeń, jakie wiosną pojawią się w zbożach ozimych, były widoczne już u schyłku jesiennego etapu wegetacji. Niestety sezon 2020 prawdopodobnie rozpocznie się od wystąpienia septoriozy paskowanej liści i rdzy żółtej, przy czym obie choroby mogą osiągnąć skalę epidemiczną. Co zrobić, aby skutki infekcji nie okazały się fatalne dla plantacji? Poznać ryzyko, zidentyfikować sprawców chorób i skorzystać ze skutecznych rozwiązań, sprawdzonych w praktyce i rekomendowanych przez ekspertów.
W opinii wielu osób zajmujących się zawodowo rolnictwem, również od strony badawczej, miesiące zimowe to na polach okres całkowitej stagnacji. Jednak ze względu na utrzymującą się w ostatnich latach tendencję do coraz łagodniejszych zim nie jest to prawdą. Chociaż zboża ozime weszły w stan spoczynku, nie oznacza to, że są wolne od zagrożeń, takich jak choroby grzybowe. Sytuacja zdecydowanie zdynamizuje się wczesną wiosną, ale już teraz warto się do tego przygotować – poznać sprawców potencjalnych chorób i zaplanować ich zwalczanie.
Diagnoza: septorioza
Późną jesienią na plantacjach pszenicy ozimej w różnych regionach Polski rolnicy zaobserwowali infekcje wywołane przez grzyby z gatunku Mycosphaerella graminicola, powodujące septoriozę paskowaną liści. Pojawienie się pyknidiów na tkankach liści już w miesiącach jesiennych jest dość typowym zjawiskiem, natomiast mniej typowe było masowe uwalnianie z nich zarodników konidialnych, przenoszonych wraz z wiatrem i wodą. Powodowało to wtórne infekcje, do których dochodziło pomiędzy roślinami, a także w obrębie jednej rośliny, na skutek przenoszenia się porażenia z liści starszych na młodsze. Na niektórych terenach, np. na Mazurach, zachodził zarówno proces infekcji pierwotnej zarodnikami workowymi, jak też wtórnej zarodnikami konidialnymi. Skala tego zjawiska okazała się na tyle duża, że w niektórych przypadkach znaczna część powierzchni asymilacyjnej została utracona. Zjawisko to jest naprawdę niebezpieczne, ponieważ zwykle jesienią powinien już zacząć się proces krzewienia zbóż. Tymczasem na polach, gdzie porażenie sięgało 80 czy nawet 100 proc. (ekonomiczny próg szkodliwości to 30-50 proc. w fazie 15-29 BBCH), dochodziło do ograniczania tego procesu. Dalszą konsekwencją będzie zdecydowanie mniejsza obsada pędów kłosonośnych, a co za tym idzie – słabsza kondycja roślin oraz redukcja plonu. Obecność pyknidiów i uwalnianie zarodników konidialnych na jesiennym etapie wegetacji to ewidentna wskazówka dla rolników, że wczesną wiosną niezbędny będzie zabieg zerowy (T0) albo wczesny zabieg zasadniczy (T1), aby uniknąć wystąpienia na plantacji trudnej do opanowania w dużym nasileniu i groźnej choroby, jaką jest septorioza paskowana liści.
Groźna rdza żółta
Drugim istotnym zagrożeniem u progu sezonu zimowego w zbożach ozimych były otwarte uredinia, czyli owocniki stadium niedoskonałego sprawcy rdzy żółtej, grzybów z gatunku Puccinia striiformis. Problem był tym większy, że dochodziło do tzw. kohabitacji (czyli do współkorzystania z jednego żywiciela) sprawców dwóch chorób – septoriozy paskowanej liści oraz właśnie rdzy żółtej. Chociaż ta druga nie była do tej pory odnotowywana w Polsce z dużą częstotliwością, to gdy już występuje, powoduje bardzo duże straty w uprawianych zbożach. Niestety z obserwacji wynika, że wiosną 2020 roku obie te choroby mogą osiągnąć skalę epidemiczną. Prawie wszystkie próby zbóż ozimych, dostarczane przez doradców i plantatorów na organizowane zimą przez firmę INNVIGO szkolenia techniczne, były porażone rdzą żółtą w zróżnicowanym nasileniu: od pojedynczych źródeł uwalniania zarodników propagacyjnych, nawet do 39 sztuk na powierzchni zaledwie 15 milimetrów kwadratowych. Wyjątkowo duże nasilenie rdzy stwierdzono na pszenżytach, żytach, jęczmieniach ozimych na polach w Wielkopolsce. Otwarte uredinia rdzy żółtej zostały zidentyfikowane również na Słowacji, a symptomy porażeń tą chorobą odnotowywane są w całej Europie Środkowej.
Dodatkowe utrudnienie stanowi fakt, że w naszej części Europy mogło dojść do zastąpienia europejskich ras sprawcy rdzy żółtej rasami himalajskimi w typie „wojownik”, które są znacznie bardziej agresywne w stosunku do żywiciela, a także dużo bardziej odporne na zwalczanie. Do infekcji dochodzi na większości odmian pszenżyta, a także na odmianach pszenic, które nie były podatne na porażenie rdzą żółtą. W niedługim czasie spodziewane jest masowe wystąpienie tych patogenów, a rolnicy mogą mieć znaczne problemy z ich kontrolą. Jeśli chodzi o stronę praktyczną, bardzo ważne jest także, aby nie pomylić rdzy żółtej z rdzą brunatną, ponieważ ta druga choroba jest bardziej podatna na działanie fungicydów.
Rdza żółta może wystąpić na polach bardzo wcześnie wiosną, ponieważ ma dość niewielkie wymagania termicznie. Kolejny rzut choroby obserwowany jest na liściu flagowym, następnie w okresie nalewania ziarna, a wtedy najczęściej nie ma już możliwości aplikacji fungicydów ze względu na wymagany okres karencji. Niestety na tym późnym etapie wegetacji najczęściej atakuje ona bardzo dotkliwie, bo w stopniu epidemicznym. Na całej powierzchni pola pojawiają się wówczas charakterystyczne plamy przypominające poparzenia roślin – nawet do 100% blaszki liściowej liścia flagowego i źdźbła może zostać w szybkim tempie zostać znekrozowana.
Po pierwsze: prawidłowe rozpoznanie
Konsekwencje zagrożeń, które jesienią wystąpiły na plantacjach zbóż ozimych, mogą okazać się naprawdę poważne. Wpływ na ich skalę będą miały warunki pogodowe w miesiącach zimowych. Po ochłodzeniu, do którego doszło na przełomie listopada i grudnia, można było zakładać, że procesy życiowe sprawców chorób, takich jak septorioza paskowana liści czy rdza żółta, uległy wyhamowaniu, zahibernowaniu. Jednak coraz częstsze występowanie zimą cieplejszych i wilgotniejszych okresów, tak jak w tym roku, może sprawić, że sprawcy chorób nadal będą przejawiać aktywność. Oznacza to, że proces porażenia roślin będzie się intensyfikował, jak również będzie wzrastał stopień ich zainfekowania.
W drugiej połowie stycznia oprócz rdzy żółtej na liściach pszenicy odnotowywano także duże porażenie chorobami podstawy źdźbła. Widoczne były też zmiany charakterystyczne dla Fusarium culmorum, co potwierdziły prowadzone badania – z prób liści pszenicy, pobranych bezpośrednio z pola produkcyjnego, wyinkubowana została fuzarioza. Sprawcy chorób fuzaryjnych byli widoczni na korzeniach i szyjkach roślin, przy czym szczególnie zaskakująca okazała się skala porażenia na liściach. Prawdopodobnie zależała ona od sytuacji w danym gospodarstwie czy regionie. W takich przypadkach bardzo istotne jest, aby dysponować narzędziami do szybkiej identyfikacji problemu, a także by mieć doświadczenie w ograniczaniu skutków tego typu zjawisk.
Co zatem mogą w tej sytuacji zrobić rolnicy? – Wiosną, nawet jeszcze przed ruszeniem wegetacji, powinniśmy monitorować swoją plantację poprzez pobieranie próbek z różnych reprezentatywnych części pól, zabierać próbki do pomieszczeń i w cieple, przy dobrym oświetleniu jak najdokładniej obserwować te rośliny, gdyż zachodzą na nich bardzo dynamiczne procesy. Trzeba sprawdzać nie tylko liście młodsze, ale również starsze, dlatego że wiele grzybów rozwija się na martwych tkankach, będąc saprofitami i pasożytami jednocześnie. Z martwych fragmentów grzyb może przenieść się na młodsze tkanki. Zwracajmy też uwagę na szyjki korzeniowe, pochewki liści, pochewki szyjek korzeniowych, węzły krzewienia i system korzeniowy, ponieważ i na nim mogą znajdować się ważne symptomy rozwoju grzybów. – radzi Andrzej Brachaczek, Dyrektor ds. badań i rozwoju w firmie INNVIGO. – Warto wiedzieć, jak wyglądają objawy poszczególnych chorób i owocniki grzybów. My pomagamy w takiej diagnozie na szkoleniach technicznych. Użytkownicy przynoszą rośliny z własnych pól i dysponując mikroskopami, analizujemy każdą próbkę pod względem zagrożeń poszczególnymi sprawcami. Określenie stopnia dojrzałości owocników danego grzyba jest najlepszą metodą oszacowania niebezpieczeństwa. Jeżeli takie owocniki są otwarte i uwalniane są z nich zarodniki, to jasna informacja, że ryzyko infekcji jest bardzo duże. Podczas szkoleń pokazujemy również, w jaki sposób samodzielnie to sprawdzić, nawet nie dysponując mikroskopem, a zwykłym szkłem powiększającym.
Po drugie: skuteczne zwalczanie
Prawidłowe rozpoznanie sprawcy choroby grzybowej umożliwia dobór skutecznego rozwiązania fungicydowego i zastosowanie go w optymalnym terminie. Jak podkreśla ekspert, kluczowe jest właśnie określenie, jakie zagrożenie występuje na danym polu: – Każdy, nawet najdroższy albo najbardziej nowoczesny preparat wykazuje niższą skuteczność, jeżeli stosuje się go w funkcji leczniczej. Oprócz tego istnieje znacznie większe ryzyko przełamania odporności. Dlatego ta wczesna diagnostyka jest bardzo ważna, żeby rolnik wiedział, z czym ma do czynienia na swojej plantacji. Kiedy stwierdzimy, że sprawca danej choroby jest w fazie, w której może bardzo szybko rozwijać się i dalej zakażać, wtedy musimy zastosować fungicydy – najlepiej oczywiście profilaktycznie. Zalecam Kier 450 SC, dlatego że zawiera trzy substancje czynne, które będą działać na szerokie spektrum chorób – nie tylko w zakresie ich rodzajów, ale również gatunków. Nawet jeżeli popełnimy błąd w obrębie jednego rodzaju, myląc gatunki, to konsekwencje tego błędu nie będą duże albo zupełnie nie będą miały znaczenia.
Fungicyd Kier 450 SC zawiera unikalną kompozycję trzech substancji czynnych: azoksystrobiny (z grupy strobiluryn), difenokonazolu (z grupy triazoli) oraz tebukonazolu (z grupy triazoli). Rekomendowany jest do stosowania zapobiegawczego i interwencyjnego przeciw chorobom grzybowym, takim jak septorioza paskowana liści pszenicy, septorioza plew, rdza brunatna pszenicy, mączniak prawdziwy zbóż i traw. Bardzo skuteczną i tanią substancją aktywną do zwalczania wszystkich gatunków rdzy jest tebukonazol, zawarty w środkach: Bukat/Ambrossio 500 SC i Kier 450 SC, szczególnie w formulacji SC (koncentrat w postaci zawiesiny). Formulacja SC pozwala zapewnić znacznie dłuższą ochronę niż w przypadku środków zawierających tebukonazol z oznaczeniem formulacji EW i EC. Dodatkowo formulacja SC tworzy trwały depozyt na powierzchni liścia i ma bardzo dobre parametry antyzmywalne.
– Wczesny zabieg Kierem jest bardzo ważny, dlatego że w jego składzie jest azoksystrobina, aż 200 g w jednym litrze. To substancja, która oprócz efektu fungicydowego oddziałuje fizjologicznie na procesy życiowe rośliny, wspomagając m.in. intensywność fotosyntezy, gospodarkę wodną czy wysycenie chlorofilu – podkreśla Andrzej Brachaczek. – Azoksystrobina, w odróżnieniu od innych strobiluryn, bardzo szybko i łatwo przenosi się w ksylemie, zabezpieczając zarówno organy nietraktowane środkiem, jak i nieistniejące podczas zabiegu. Dlatego łan opryskany wcześnie Kierem 450 SC na pewno będzie znacznie lepiej wyglądał i dużo szybciej się rozwijał. A jeśli chodzi o straty wywołane przez jesienne infekcje, będzie można częściowo nadrobić je wiosną, pobudzając krzewienie regulatorami wzrostu – rekomendujemy Mepik 300 SL, zawierający chlorek mepikwatu – stosując środki, które stymulują rozwój systemu korzeniowego, jak Regullo 500 EC z trineksapakiem etylu, oraz wzmagając wydajność fotosyntezy dzięki azoksystrobinie, zawartej w środkach Kier 450 SC i Makler 250 SE.
Źródło: materiały prasowe INNVIGO

0 komentarzy
Rekomendowane komentarze
Brak komentarzy do wyświetlenia